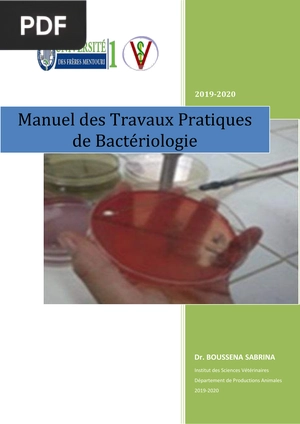
Manuel des Travaux Pratiques de Bactériologie
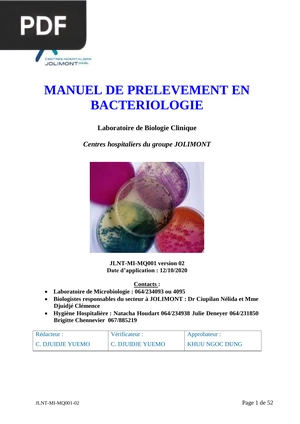
Manuel de prelevement en bacteriologie

15 Livres de Bactériologie Médicale Gratuits en PDF
par InfoLivres

La bactériologie médicale étudie les bactéries qui colonisent l'organisme et les pathologies qu'elles déclenchent. Vous trouverez ici 15 livres de bactériologie médicale gratuits en PDF : cours universitaires, manuels de travaux pratiques et guides de prélèvements.
Chaque PDF provient de facultés de médecine, d'unités hospitalières ou de sociétés savantes francophones. Vous y découvrirez les fondamentaux : identification des germes, milieux de culture, ensemencement, antibiogramme et diagnostic bactériologique.
Discipline transverse de la biologie médicale, la bactériologie nourrit la microbiologie clinique et l'infectiologie. Étudiants en médecine, internes en biologie médicale et techniciens de laboratoire trouveront ici de quoi structurer leur apprentissage.
Téléchargez la collection complète de livres de bactériologie
Tous les livres de cette page dans un seul fichier ZIP, au lieu de les télécharger un par un.
Nous allons vous rediriger vers accounts.google.com pour finaliser la connexion.
Juste votre e-mail et votre nom. Pas de spam.
Téléchargez la collection complète de livres de bactériologie
Tous les livres de cette page dans un seul fichier ZIP, au lieu de les télécharger un par un.
Téléchargement direct. Un seul fichier ZIP.
Téléchargement lancé. Le fichier ZIP arrive dans votre dossier de téléchargements.
Livres de Bactériologie Médicale
Les ouvrages de référence ci-dessous présentent la bactériologie médicale dans son ensemble : taxonomie, physiologie bactérienne et bactéries d'intérêt clinique. Cours universitaires et fiches pédagogiques pour étudiants en médecine, pharmacie ou internat de biologie médicale.
Livres de Travaux Pratiques et Prélèvements en Bactériologie
La qualité du prélèvement détermine la fiabilité du diagnostic bactériologique. Ces manuels détaillent les techniques de prélèvement par site (urine, sang, voies respiratoires) et les bonnes pratiques au laboratoire.
Livres d'Antibiogramme et Résistance Bactérienne
L'antibiogramme oriente la prescription et combat la résistance aux antibiotiques. Cette recommandation officielle CA-SFM/EUCAST 2025 fournit les seuils cliniques et les mécanismes de résistance à connaître.
Livres de Bactériologie Clinique et Systématique
La bactériologie clinique et systématique couvre la structure, la physiologie et la taxonomie des bactéries d'intérêt médical. Ces cours abordent les staphylocoques, streptocoques, mycobactéries et bactéries des diarrhées avec une approche diagnostique.
Livres d'Automatisation et Bactériologie Spécialisée
L'automatisation transforme la bactériologie clinique : MALDI-TOF, automates de culture et de sensibilité accélèrent l'identification. Cette sélection complète l'approche générale par des applications spécialisées en cancérologie et en agroalimentaire.
Cette collection rassemble les fondamentaux pour structurer votre formation en bactériologie médicale, de la microscopie au diagnostic moléculaire. Ouvrez chaque PDF directement dans le navigateur ou enregistrez-les sur vos appareils.
Pour élargir vos recherches, explorez l'ensemble des livres de biologie en PDF de notre collection.